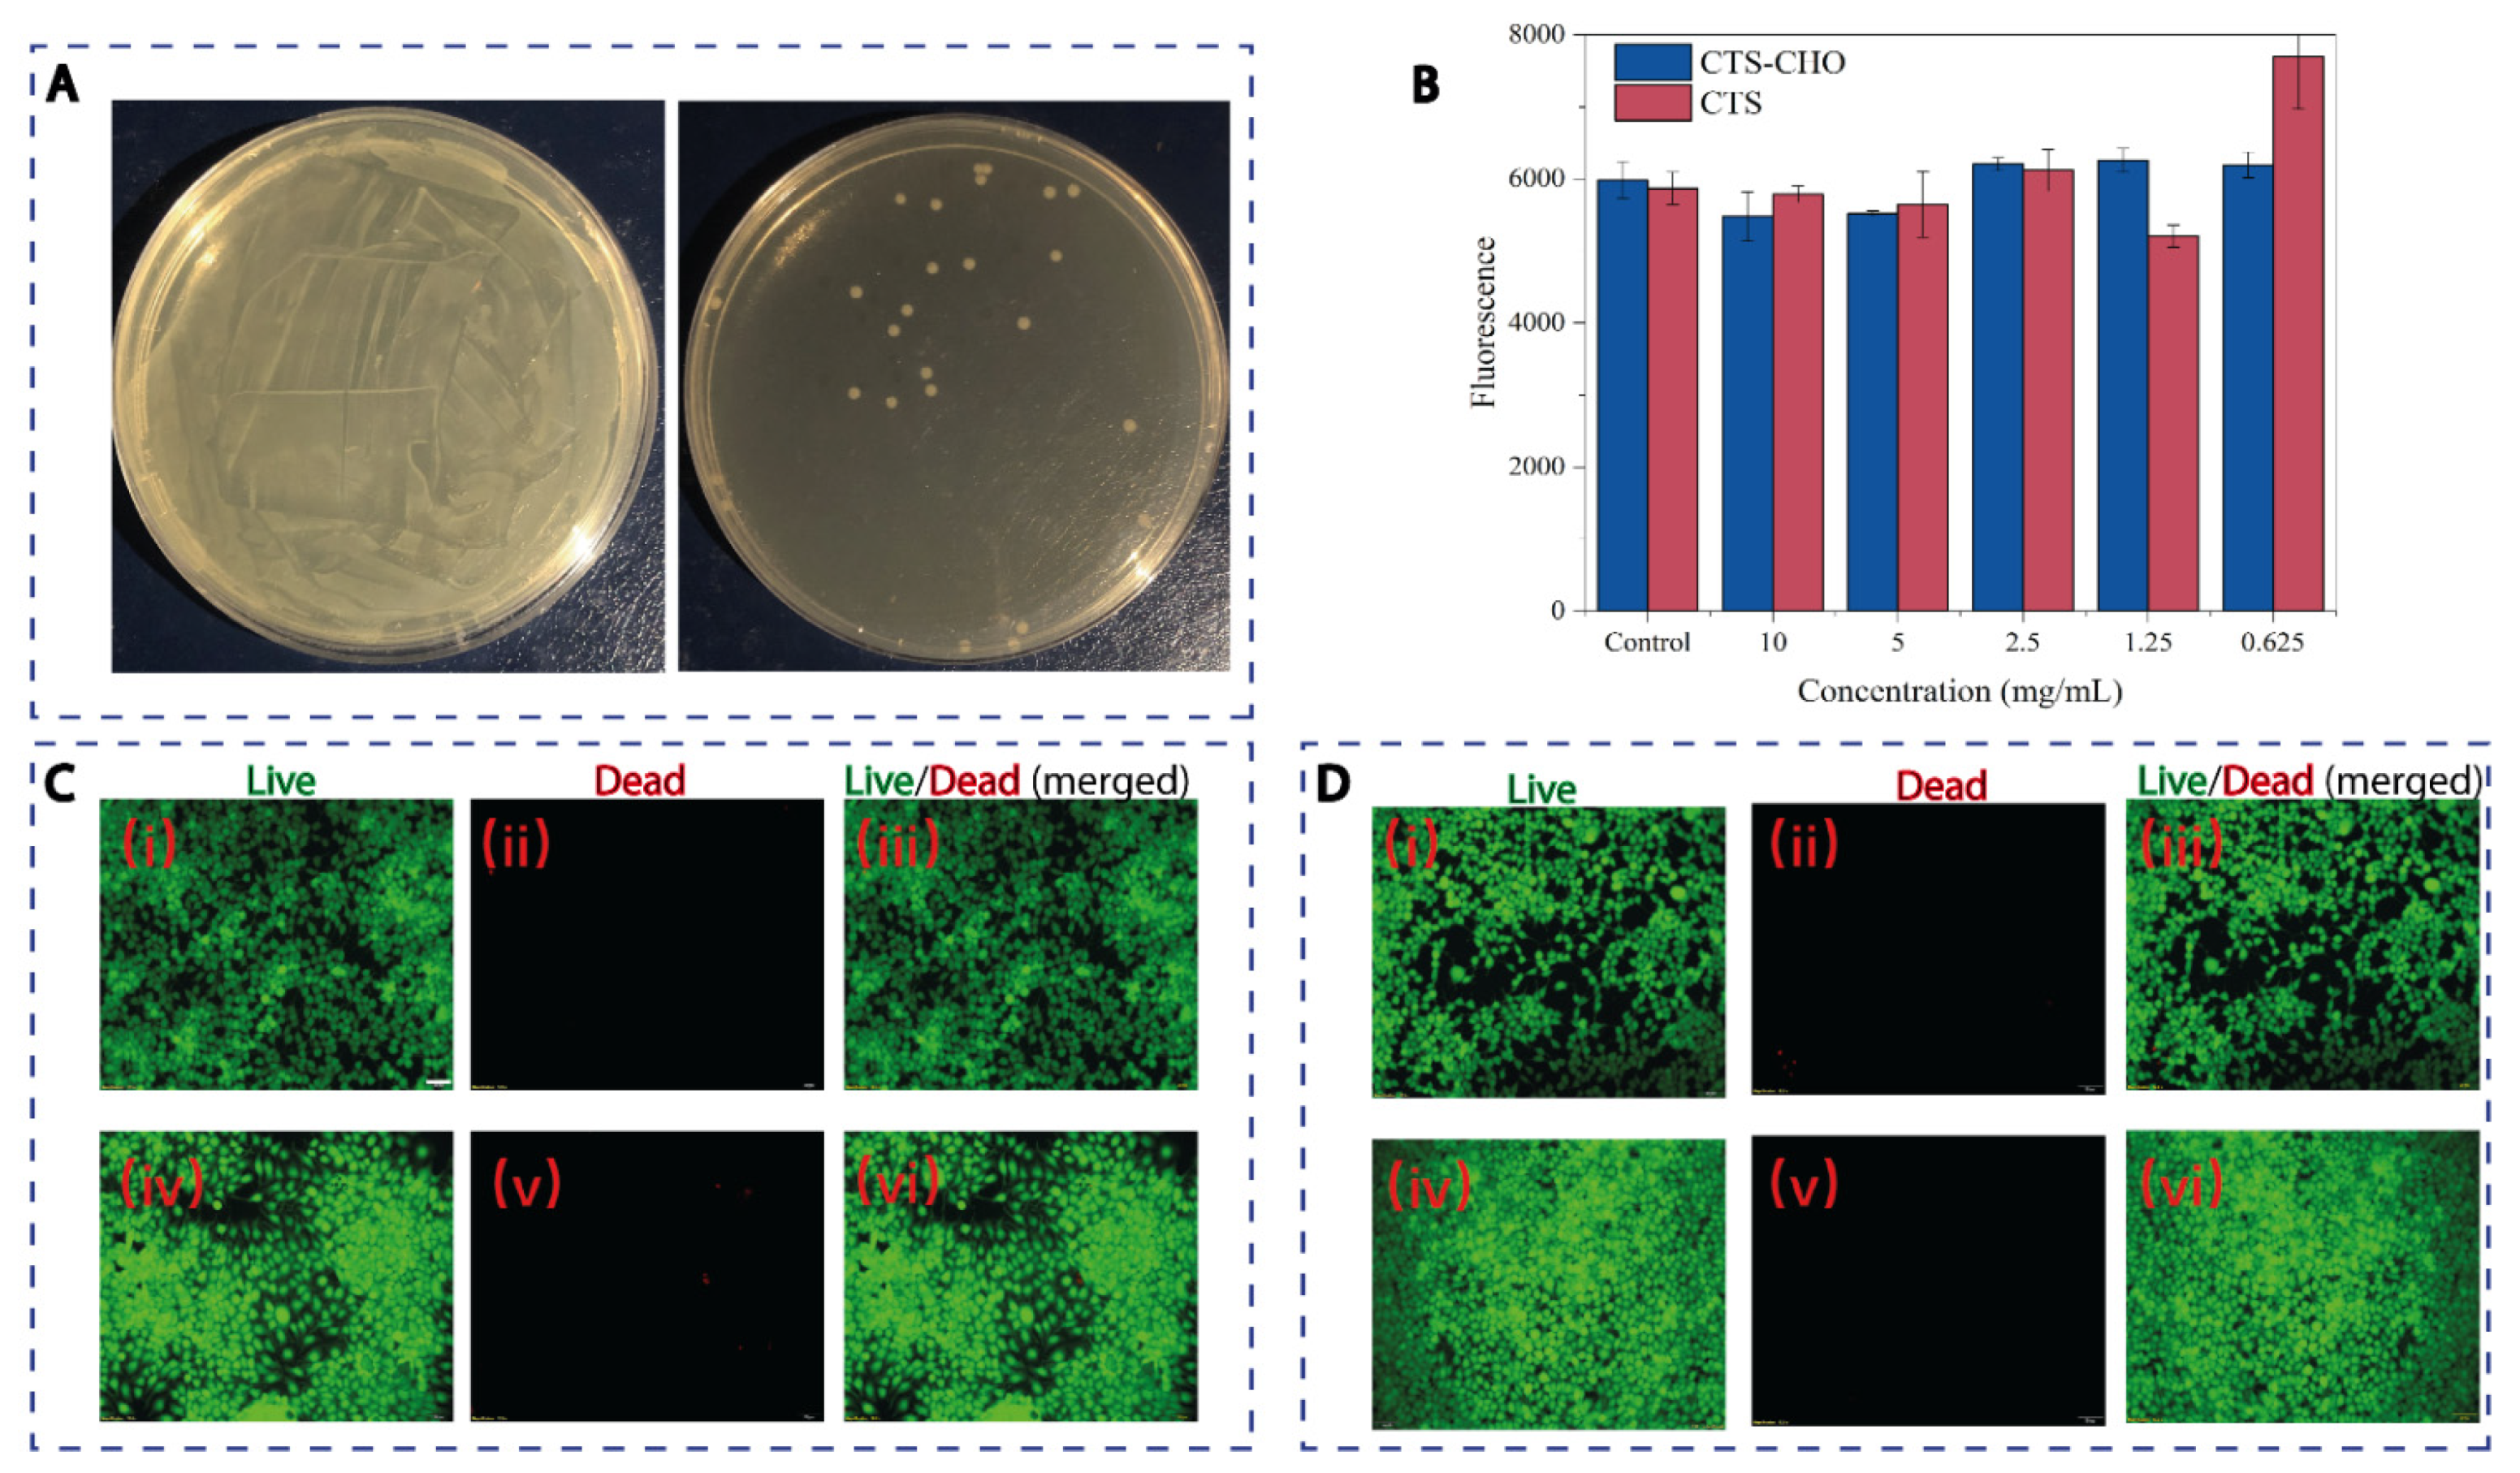
Materials 14 05956 g004 Materials 14 05956 g004

An Injectable Chitosan-Based Self-Healable Hydrogel System as an Antibacterial Wound Dressing
Abstract
1. Introduction
2. Materials and Methods
2.1. Materials
2.2. Preparation and Characterization of Dialdehyde Chitosan
2.2.1. Preparation of Dialdehyde Chitosan
2.2.2. Fourier Transform Infrared Spectrometry
2.2.3. Element Analysis
2.2.4. Bacteria Culture
2.2.5. Agar Diffusion Assay
2.3. Preparation and Characterization of Chitosan-Based Hydrogel
2.3.1. Preparation of Chitosan-Based Hydrogel
2.3.2. Rheological Test
2.3.3. Degradation Test
2.3.4. Self-Healable and Injectable Properties
2.3.5. Anti-Bacterial Property
2.4. In Vitro Cytotoxicity Assessment
2.4.1. Cytotoxicity of Materials
2.4.2. Cytotoxicity of Hydrogel
3. Results and Discussion
3.1. Preparation and Characterization of Dialdehyde Chitosan (CTS–CHO)
3.2. Preparation and Characterization of Chitosan-Based Hydrogel
4. Conclusions
Supplementary Materials
Author Contributions
Funding
Institutional Review Board Statement
Informed Consent Statement
Data Availability Statement
Conflicts of Interest
References
- Suarato, G.; Bertorelli, R.; Athanassiou, A. Borrowing From Nature: Biopolymers and Biocomposites as Smart Wound Care Materials. Front. Bioeng. Biotechnol. 2018, 6, 137. [Google Scholar] [CrossRef] [PubMed]
- Zhang, X.; Qin, M.; Xu, M.; Miao, F.; Merzougui, C.; Zhang, X.; Wei, Y.; Chen, W.; Huang, D. The fabrication of antibacterial hydrogels for wound healing. Eur. Polym. J. 2021, 146, 110268. [Google Scholar] [CrossRef]
- Xue, W.; Zhang, F.; Wang, F.; Gao, J.; Wang, L. Long-term durability antibacterial microcapsules with plant-derived Chinese nutgall and their applications in wound dressing. e-Polymers 2019, 19, 268–276. [Google Scholar] [CrossRef]
- Sharma, P.K.; Halder, M.; Srivastava, U.; Singh, Y. Antibacterial PEG-Chitosan Hydrogels for Controlled Antibiotic/Protein Delivery. ACS Appl. Bio Mater. 2019, 2, 5313–5322. [Google Scholar] [CrossRef]
- Cook, L.; Ousey, K. Demystifying wound infection: Identification and management. Pract. Nurs. 2011, 22, 424–428. [Google Scholar] [CrossRef][Green Version]
- Li, S.; Dong, S.; Xu, W.; Tu, S.; Yan, L.; Zhao, C.; Ding, J.; Chen, X. Antibacterial Hydrogels. Adv. Sci. 2018, 5, 1700527. [Google Scholar] [CrossRef]
- Balakrishnan, B.; Mohanty, M.; Umashankar, P.; Jayakrishnan, A. Evaluation of an in situ forming hydrogel wound dressing based on oxidized alginate and gelatin. Biomaterials 2005, 26, 6335–6342. [Google Scholar] [CrossRef]
- El-Banna, F.S.; Mahfouz, M.E.; Leporatti, S.; El-Kemary, M.; Hanafy, N.A.N. Chitosan as a Natural Copolymer with Unique Properties for the Development of Hydrogels. Appl. Sci. 2019, 9, 2193. [Google Scholar] [CrossRef]
- Sahariah, P.; Másson, M. Antimicrobial Chitosan and Chitosan Derivatives: A Review of the Structure–Activity Relationship. Biomacromolecules 2017, 18, 3846–3868. [Google Scholar] [CrossRef] [PubMed]
- Díez-Pascual, A.M.; Díez-Vicente, A.L. Wound Healing Bionanocomposites Based on Castor Oil Polymeric Films Reinforced with Chitosan-Modified ZnO Nanoparticles. Biomacromolecules 2015, 16, 2631–2644. [Google Scholar] [CrossRef] [PubMed]
- Kong, M.; Chen, X.G.; Xing, K.; Park, H.J. Antimicrobial properties of chitosan and mode of action: A state of the art review. Int. J. Food Microbiol. 2010, 144, 51–63. [Google Scholar] [CrossRef]
- Wegrzynowska-Drzymalska, K.; Grebicka, P.; Mlynarczyk, D.T.; Chelminiak-Dudkiewicz, D.; Kaczmarek, H.; Goslinski, T.; Ziegler-Borowska, M. Crosslinking of Chitosan with Dialdehyde Chitosan as a New Approach for Biomedical Applications. Materials 2020, 13, 3413. [Google Scholar] [CrossRef] [PubMed]
- Jiang, X.; Yang, Z.; Peng, Y.; Han, B.; Li, Z.; Li, X.; Liu, W. Preparation, characterization and feasibility study of dialdehyde carboxymethyl cellulose as a novel crosslinking reagent. Carbohydr. Polym. 2016, 137, 632–641. [Google Scholar] [CrossRef] [PubMed]
- Mahdavinia, G.R.; Pourjavadi, A.; Zohuriaan-Mehr, M.J. Synthesis and Properties of Highly Swelling PAAm/Chitosan Semi-IPN Hydrogels. Macromol. Symp. 2008, 274, 171–176. [Google Scholar] [CrossRef]
- Zhang, W.; Yu, Z.; Qian, Q.; Zhang, Z.; Wang, X. Improving the pervaporation performance of the glutaraldehyde crosslinked chitosan membrane by simultaneously changing its surface and bulk structure. J. Membr. Sci. 2010, 348, 213–223. [Google Scholar] [CrossRef]
- Jin, J.; Song, A.M.; Hourston, D.J. Novel Chitosan-Based Films Cross-Linked by Genipin with Improved Physical Properties. Biomacromolecules 2004, 5, 162–168. [Google Scholar] [CrossRef] [PubMed]
- Capáková, Z.; Fi, M.; Ku, I.; Vícha, J. Biocompatible Dialdehyde Cellulose/Poly (Vinyl Alcohol) Hydrogels with Tunable Properties. Carbohydr. Polym. 2019, 218, 549. [Google Scholar]
- Hafezi, F.; Scoutaris, N.; Douroumis, D.; Boateng, J. 3D printed chitosan dressing crosslinked with genipin for potential healing of chronic wounds. Int. J. Pharm. 2019, 560, 406–415. [Google Scholar] [CrossRef] [PubMed]
- Charhouf, I.; Bennamara, A.; Abdelmjid, A.; Berrada, M. Characterization of a Dialdehyde Chitosan Generated by Periodate Oxidation International Journal of Sciences: Basic and Applied Research Characterization of a Dialdehyde Chitosan Generated by Periodate Oxidation. Biosensors 2014, 16, 18. [Google Scholar]
- Lv, Y.; Long, Z.; Song, C.; Dai, L.; He, H.; Wang, P. Preparation of Dialdehyde Chitosan and its Application in Green Synthesis of Silver Nanoparticles. BioResources 2013, 8, 6161–6172. [Google Scholar] [CrossRef]
- Vold, I.M.; Christensen, B.E. Periodate oxidation of chitosans with different chemical compositions. Carbohydr. Res. 2005, 340, 679–684. [Google Scholar] [CrossRef] [PubMed]
- Liu, X.; Dan, N.; Dan, W.; Gong, J. Feasibility study of the natural derived chitosan dialdehyde for chemical modification of collagen. Int. J. Biol. Macromol. 2016, 82, 989–997. [Google Scholar] [CrossRef] [PubMed]
- Bam, P.; Bhatta, A.; Krishnamoorthy, G. Design of biostable scaffold based on collagen crosslinked by dialdehyde chitosan with presence of gallic acid. Int. J. Biol. Macromol. 2019, 130, 836–844. [Google Scholar] [CrossRef]
- Yin, M.; Wang, Y.; Zhang, Y.; Ren, X.; Qiu, Y.; Huang, T.-S. Novel quaternarized N-halamine chitosan and polyvinyl alcohol nanofibrous membranes as hemostatic materials with excellent antibacterial properties. Carbohydr. Polym. 2020, 232, 115823. [Google Scholar] [CrossRef] [PubMed]
- Kumar, S.; Koh, J. Physiochemical, Optical and Biological Activity of Chitosan-Chromone Derivative for Biomedical Applications. Int. J. Mol. Sci. 2012, 13, 6102–6116. [Google Scholar] [CrossRef] [PubMed]
- Wei, D.; Sun, W.; Qian, W.; Ye, Y.; Ma, X. The synthesis of chitosan-based silver nanoparticles and their antibacterial activity. Carbohydr. Res. 2009, 344, 2375–2382. [Google Scholar] [CrossRef] [PubMed]
- Mozafari, M.; Moztarzadeh, F.; Jalali, N.; Alhosseini, S.N.; Asgari, S.; Dodel, M.; Samadikuchaksaraei, A.; Kargozar, S. Synthesis and characterization of electrospun polyvinyl alcohol nanofibrous scaffolds modified by blending with chitosan for neural tissue engineering. Int. J. Nanomed. 2012, 7, 25–34. [Google Scholar] [CrossRef] [PubMed]
- Jeong, Y.-I.; Kim, D.-G.; Jang, M.-K.; Nah, J.-W. Preparation and spectroscopic characterization of methoxy poly(ethylene glycol)-grafted water-soluble chitosan. Carbohydr. Res. 2008, 343, 282–289. [Google Scholar] [CrossRef] [PubMed]
- Mahmoudzadeh, M.; Fassihi, A.; Emami-Baferani, J.; Davies, N.M.; Dorkoosh, F. Physicochemical, pharmaceutical and biological approaches toward designing optimized and efficient hydrophobically modified chitosan-based polymeric micelles as a nanocarrier system for targeted delivery of anticancer drugs. J. Drug Target. 2013, 21, 693–709. [Google Scholar] [CrossRef] [PubMed]
- Hoque, J.; Bhattacharjee, B.; Prakash, R.G.; Paramanandham, K.; Haldar, J. Dual Function Injectable Hydrogel for Controlled Release of Antibiotic and Local Antibacterial Therapy. Biomacromolecules 2017, 19, 267–278. [Google Scholar] [CrossRef]
- Hozumi, T.; Kageyama, T.; Ohta, S.; Fukuda, J.; Ito, T. Injectable Hydrogel with Slow Degradability Composed of Gelatin and Hyaluronic Acid Cross-Linked by Schiff’s Base Formation. Biomacromolecules 2018, 19, 288–297. [Google Scholar] [CrossRef] [PubMed]
- Jennings, J. Controlling Chitosan Degradation Properties In Vitro and In Vivo; Elsevier: Amsterdam, The Netherlands, 2017; Volume 1. [Google Scholar] [CrossRef]
- Gong, Z.; Yang, Y.; Ren, Q.; Chen, X.; Shao, Z. Injectable thixotropic hydrogel comprising regenerated silk fibroin and hydroxypropylcellulose. Soft Matter 2012, 8, 2875–2883. [Google Scholar] [CrossRef]

Publisher’s Note: MDPI stays neutral with regard to jurisdictional claims in published maps and institutional affiliations. |
© 2021 by the authors. Licensee MDPI, Basel, Switzerland. This article is an open access article distributed under the terms and conditions of the Creative Commons Attribution (CC BY) license (https://creativecommons.org/licenses/by/4.0/).
Share and Cite
Wang, X.; Song, R.; Johnson, M.; A, S.; He, Z.; Milne, C.; Wang, X.; Lara-Sáez, I.; Xu, Q.; Wang, W. An Injectable Chitosan-Based Self-Healable Hydrogel System as an Antibacterial Wound Dressing. Materials 2021, 14, 5956. https://doi.org/10.3390/ma14205956
Wang X, Song R, Johnson M, A S, He Z, Milne C, Wang X, Lara-Sáez I, Xu Q, Wang W. An Injectable Chitosan-Based Self-Healable Hydrogel System as an Antibacterial Wound Dressing. Materials. 2021; 14(20):5956. https://doi.org/10.3390/ma14205956
Chicago/Turabian StyleWang, Xiaoyu, Rijian Song, Melissa Johnson, Sigen A, Zhonglei He, Cameron Milne, Xianqing Wang, Irene Lara-Sáez, Qian Xu, and Wenxin Wang. 2021. "An Injectable Chitosan-Based Self-Healable Hydrogel System as an Antibacterial Wound Dressing" Materials 14, no. 20: 5956. https://doi.org/10.3390/ma14205956
APA StyleWang, X., Song, R., Johnson, M., A, S., He, Z., Milne, C., Wang, X., Lara-Sáez, I., Xu, Q., & Wang, W. (2021). An Injectable Chitosan-Based Self-Healable Hydrogel System as an Antibacterial Wound Dressing. Materials, 14(20), 5956. https://doi.org/10.3390/ma14205956

